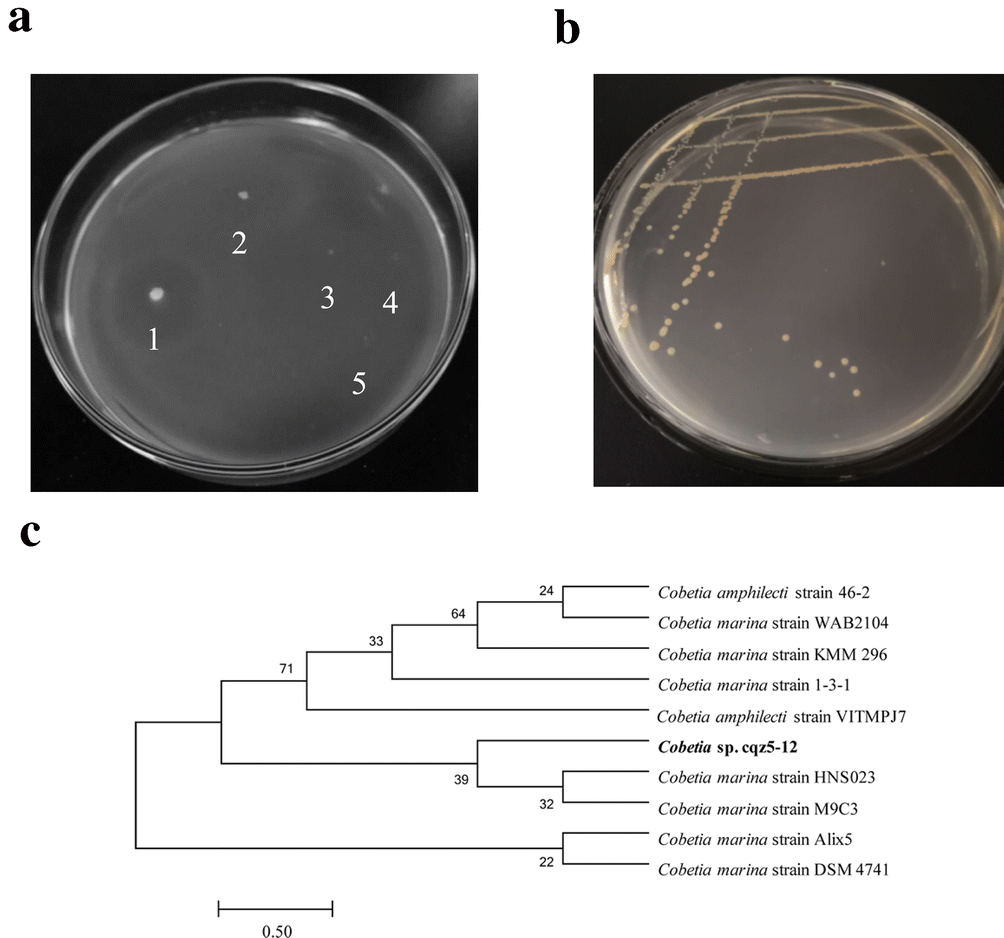
Figure 1

Figure 1
Degradation effect of alginate-degrading bacterium Cobetia sp. cqz5-12 on a plate containing sodium alginate and identification of the strain. (a) The results of plate degradation of alginate-degrading bacteria. 1: Cobetia sp. cqz5-12 with degradation effect, 2–5: the strains that lack the ability to degrade sodium alginate. (b) The colony morphology of Cobetia sp. cqz5-12 on solid medium A containing 3% NaCl. The photographs in (a) and (b) were captured by co-author Wenwen Cheng using camera (Sony, DSC-P51, USA) at laboratory in WenZhou University. (c) The construction of a phylogenetic tree using MEGA 7.0 software. The analysis of the self-expansion was performed after 1,000 times of repeated sampling by the Neighbor-joining method53.
